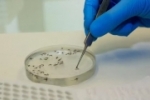
Rond&ocirc;nia &eacute; o 2° Estado do pa&iacute;s com mais casos de Febre Oropouche em 2024, aponta Minist&eacute;rio da Sa&uacute;de &ndash; Ariquemes est&aacute; no ranking

Rondônia

Homem é preso após tentar matar desafeto a facada na zona norte
05/10/2024A chegada rápida de policiais do 1º Batalhão evitou um crime de homicídio na madrugada deste sábado (05), na Rua Cecília Meireles, bairro São Sebastião, zona norte.... Leia Mais

PM faz apreensão de drogas e prende duas mulheres em Ji–Paraná
05/10/2024No final da amanhã desta sexta–feira (04), a guarnição composta pelo SGT PM Teodoro e CB PM Sikeira estouraram uma “boca de fumo” na T–20 com rua Amapá, bairro Jk.... Leia Mais

PRF realiza apreensão de 415 kg de skunk em Vilhena
05/10/2024Rondônia, 04/10/2024 – A Polícia Rodoviária Federal (PRF) em Rondônia, na noite da última quinta–feira (03), realizou a segunda apreensão histórica na cidade de Vilhena/RO.... Leia Mais

PF e PM/RO atuam em flagrante de candidato encontrado com dinheiro não declarado
04/10/2024Nesta quinta–feira, 3/10, a Polícia Federal fez de prisão em flagrante em desfavor de candidato que transportava.... Leia Mais

POLÍCIA CIVIL DEFLAGRA 2ª FASE DA OPERAÇÃO "LAMBUJA" EM INVESTIGAÇÃO SOBRE DESVIO DE VERBAS PÚBLICAS
04/10/2024Na manhã de hoje (04), a Polícia Civil do Estado de Rondônia.... Leia Mais

AÇÃO RÁPIDA: POLÍCIA CIVIL PRENDE SUSPEITO DE SEQUESTRO E ESTUPRO DE VULNERÁVEL EM NOVA MAMORÉ
04/10/2024Na tarde de quarta (02), a Polícia Civil de Rondônia, por meio da Delegacia de Nova Mamoré, em conjunto com a Polícia Militar.... Leia Mais

FICCO/RO prende dois indivíduos por tentativa de roubo em uma residência
03/10/2024Porto Velho/RO. A Força Integrada de Combate ao Crime Organizado em Rondônia (FICCO/RO) prendeu nesta quarta–feira, 2/10, após denúncia anônima, dois indivíduos.... Leia Mais

POLÍCIA CIVIL DEFLAGRA "OPERAÇÃO ESCUDO DE CINZAS – FASE MANILKARA" CONTRA CRIMES AMBIENTAIS EM RONDÔNIA
03/10/2024Nesta quinta–feira (03), a Polícia Civil do Estado de Rondônia, por meio da 2ª Delegacia de Repressão ao Crime Organizado (DRACO–II).... Leia Mais

Coronel Chrisóstomo: a população acordou e Desaprovação a Lula dispara em meio a aumento a crise na economia e corrupção
03/10/2024A justiça popular pode até tardar, mas não falha. A desaprovação ao governo.... Leia Mais

PRF e BPFRON realizam apreensão de drogas e submetralhadora em Porto Velho/RO
03/10/2024Rondônia, 03/10/2024 – A Polícia Rodoviária Federal (PRF) em Rondônia, na noite desta quarta–feira.... Leia Mais

Crédito aprovado à Sedam NÃO é para fiscalizações na Resex Jaci–Paraná; ENTENDA O PROJETO
02/10/2024É falsa a informação, que circula em redes sociais, de que o Projeto de Lei Ordinária (PLO) aprovando R$ 1,5 milhão em crédito.... Leia Mais

Homem é atacado com socos, chutes e facadas no bairro Socialista
02/10/2024Um homem de 41 anos foi esfaqueado por uma dupla que fugiu após o atentado. A vítima foi socorrida para a UPA e contou para a polícia que estava chegando em casa.... Leia Mais

Homem é atacado a facadas pelo filho da ex–mulher na zona leste
02/10/2024Um homem de 26 anos sofreu uma tentativa de homicídio a facadas na noite desta terça–feira (01), na Rua Acesso Afonso Brasil, bairro Jardim Santana, zona leste de Porto Velho.... Leia Mais

Defesa Civil Municipal orienta população em casos de chuvas intensas, ventos fortes e alagamentos
02/10/2024Apesar de desejadas pelos moradores de Porto Velho, devido à severa estiagem dos últimos meses, as fortes chuvas e ventos.... Leia Mais

Ciclista e motociclista são socorridos após colisão no centro
02/10/2024Segundo informações o ciclista acabou sendo atingido pelo condutor da moto Bros que seguia na Barão de Melgaço sentido Santa Luzia, ambos sofreram ferimentos leves, mas, precisaram ser.... Leia Mais

Homem é preso após agredir familiares e policiais militares em ocorrência
02/10/2024No início da noite desta terça–feira (02), a Polícia Militar foi acionada para uma ocorrência de violência na rua Beira Rio, bairro Duque de Caxias, segundo distrito de Ji–Paraná.... Leia Mais

Motocicleta furtada em Vilhena é recuperada em Cacoal
02/10/2024Na tarde desta terça–feira, 01, uma motocicleta Honda Bros que havia sido furtada há quase três semanas em Vilhena e seria trocada por drogas na cidade de Costa Marques, que fica na.... Leia Mais

POLÍCIA CIVIL CUMPRE MANDADO DE PRISÃO E APREENSÃO DE ARMA EM MACHADINHO D'OESTE
01/10/2024Na tarde desta segunda–feira (30), a Polícia Civil de Rondônia, por intermédio da Delegacia de Machadinho d’Oeste.... Leia Mais

Força Tática prende homem vendendo drogas em antiga cerâmica no bairro Primavera em Ji–Paraná – Vídeo
30/09/2024Acompanhe a notícia pelo programa Bronca da Pesada. Assista de segunda à sexta–feira a partir das 11 horas.... Leia Mais

Motociclista morre ao bater de frente com carreta na BR 364 entre Ji–Paraná e Presidente Médici – Vídeo
30/09/2024Acompanhe a notícia pelo programa Bronca da Pesada. Assista de segunda à sexta–feira a partir das 11 horas.... Leia Mais

POLÍCIA CIVIL DEFLAGRA OPERAÇÃO “ASFIXIA” EM CEREJEIRAS
30/09/2024Na manhã desta segunda–feira (30), a Polícia Civil de Rondônia, por meio da Delegacia de Cerejeiras, com o apoio das Delegacias de Vilhena e Colorado do Oeste, bem como.... Leia Mais

POLÍCIA CIVIL DE RONDÔNIA PRENDE INVESTIGADO POR DUPLO ESTUPRO EM AÇÃO CONJUNTA ENTRE DEPCA E 1ª DP DE CANDEIAS DO JAMARI
30/09/2024Na manhã deste sábado (28), a Polícia Civil de Rondônia, por meio da Delegacia Especializada em.... Leia Mais

AÇÃO INTEGRADA RESULTA NA PRISÃO DE DOIS SUSPEITOS DE ROUBO EM ALVORADA DO OESTE
30/09/2024Na noite da última quarta–feira (25), uma operação conjunta entre a Polícia Civil e a Polícia Militar levou à prisão.... Leia Mais

Operação da Polícia Civil prende integrante do Corpo de Bombeiros envolvido em esquema de fraude financeira de R$ 4 milhões
30/09/2024A Delegacia Especializada em Repressão Às Fraudes .... Leia Mais
Empresário fundador da Folha de Rondônia e pecuarista é assassinado na Bolívia
29/09/2024Ex–vereador em Ji–Paraná, o empresário Pedro André.... Leia Mais
www.ariquemes190.com.br
Copyright © 2008 - 2026 Todos os direitos reservados
Site desenvolvido por Prospect Plus

















